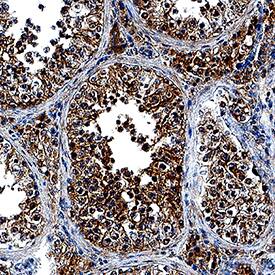
RNF4 antibody in Human Testis by Immunohistochemistry (IHC-P).

Human RNF4 Antibody
R&D Systems, part of Bio-Techne | Catalog # AF7964


Conjugate
Catalog #
Key Product Details
Validated by
Biological Validation
Species Reactivity
Validated:
Human
Cited:
Human, Xenograft
Applications
Validated:
Immunohistochemistry, Western Blot, Immunocytochemistry
Cited:
Western Blot, Western Blots
Label
Unconjugated
Antibody Source
Polyclonal Goat IgG
Product Specifications
Immunogen
E.coli-derived recombinant human RNF4
Met1-Ile190
Accession # P78317
Met1-Ile190
Accession # P78317
Specificity
Detects human RNF4 in direct ELISAs and Western blots.
Clonality
Polyclonal
Host
Goat
Isotype
IgG
Scientific Data Images for Human RNF4 Antibody
Detection of Human RNF4 by Western Blot.
Western blot shows lysates of GM00719D human ataxia telangiectasia cell line either mock-treated (-) or exposed (+) to 10 Gy ionizing radiation (IR) and harvested after 1 hour, BaF3 mouse pro-B cell line, and LNCaP human prostate cancer cell line. PVDF membrane was probed with 1 µg/mL of Goat Anti-Human RNF4 Antigen Affinity-purified Polyclonal Antibody (Catalog # AF7964) followed by HRP-conjugated Anti-Goat IgG Secondary Antibody (Catalog # HAF017). A specific band was detected for RNF4 at approximately 34 kDa (as indicated). This experiment was conducted under reducing conditions and using Immunoblot Buffer Group 1.RNF4 in HeLa Human Cell Line.
RNF4 was detected in immersion fixed HeLa human cervical epithelial carcinoma cell line using Goat Anti-Human RNF4 Antigen Affinity-purified Polyclonal Antibody (Catalog # AF7964) at 1.7 µg/mL for 3 hours at room temperature. Cells were stained using the NorthernLights™ 557-conjugated Anti-Goat IgG Secondary Antibody (red; Catalog # NL001) and counterstained with DAPI (blue). Specific staining was localized to nuclei and cytoplasm. View our protocol for Fluorescent ICC Staining of Cells on Coverslips.RNF4 in Human Testis.
RNF4 was detected in immersion fixed paraffin-embedded sections of human testis using Goat Anti-Human RNF4 Antigen Affinity-purified Polyclonal Antibody (Catalog # AF7964) at 10 µg/mL overnight at 4 °C. Tissue was stained using the Anti-Goat HRP-DAB Cell & Tissue Staining Kit (brown; Catalog # CTS008) and counterstained with hematoxylin (blue). Specific staining was localized to nuclei and cytoplasm. View our protocol for Chromogenic IHC Staining of Paraffin-embedded Tissue Sections.Applications for Human RNF4 Antibody
Application
Recommended Usage
Immunocytochemistry
1-15 µg/mL
Sample: Immersion fixed HeLa human cervical epithelial carcinoma cell line
Sample: Immersion fixed HeLa human cervical epithelial carcinoma cell line
Immunohistochemistry
1-15 µg/mL
Sample: Immersion fixed paraffin-embedded sections of human testis
Sample: Immersion fixed paraffin-embedded sections of human testis
Western Blot
1 µg/mL
Sample: GM00719D human ataxia telangiectasia cell line exposed to 10 Gy ionizing radiation (IR) and harvested after 1 hour, BaF3 mouse pro-B cell line, and LNCaP human prostate cancer cell line
Sample: GM00719D human ataxia telangiectasia cell line exposed to 10 Gy ionizing radiation (IR) and harvested after 1 hour, BaF3 mouse pro-B cell line, and LNCaP human prostate cancer cell line
Reviewed Applications
Read 1 review rated 4 using AF7964 in the following applications:
Formulation, Preparation, and Storage
Purification
Antigen Affinity-purified
Reconstitution
Reconstitute at 0.2 mg/mL in sterile PBS. For liquid material, refer to CoA for concentration.
Formulation
Lyophilized from a 0.2 μm filtered solution in PBS with Trehalose. *Small pack size (SP) is supplied either lyophilized or as a 0.2 µm filtered solution in PBS.
Shipping
Lyophilized product is shipped at ambient temperature. Liquid small pack size (-SP) is shipped with polar packs. Upon receipt, store immediately at the temperature recommended below.
Stability & Storage
Use a manual defrost freezer and avoid repeated freeze-thaw cycles.
- 12 months from date of receipt, -20 to -70 °C as supplied.
- 1 month, 2 to 8 °C under sterile conditions after reconstitution.
- 6 months, -20 to -70 °C under sterile conditions after reconstitution.
Background: RNF4
RNF4 (small nuclear ring finger protein, SNURF) is a RING-finger ubiquitin E3 ligase that ubiquitinates and mediates the proteasomal destruction of targets such as PML, PEA3, CENP1, and PARP1. In addition to the RING domain, RNF4 contains four SUMO-interacting motifs (SIMs) that function to recruit this ligase to poly-sumoylated substrates. RNF4 will autoubiquitinate in vitro, and will also ubiquitinate poly-SUMO chains.
References
-
Geoffroy, M-C et al. (2010) Mol. Bio. Cell 21: 4227
-
Tathum, M.H. et al. (2008) Nat. Cell Bio. 10: 538
Long Name
Ring Finger Protein 4
Alternate Names
RES4-26, SLX5, SNURF
Entrez Gene IDs
6047 (Human)
Gene Symbol
RNF4
UniProt
Additional RNF4 Products
Product Documents for Human RNF4 Antibody
Product Specific Notices for Human RNF4 Antibody
For research use only
Loading...
Loading...
Loading...
Loading...
Loading...